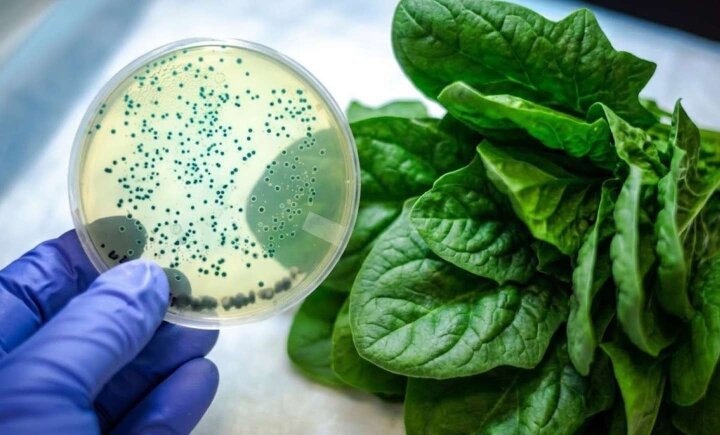

Summary: A chemical engineer’s discovery is quietly changing how health-conscious families clean their food — and it has nothing to do with soap, vinegar, or any produce wash you’ve seen before. You rinse strawberries under the tap, pop one straight in your mouth, and don’t give it a second thought. Most of us don’t. But here’s what you possibly just ate: That just changed. A food safety researcher has now taken electrolysis technology — previously locked inside industrial food processing plants — and built it into a device that fits in the palm of your hand. “Running tap water removes less than 30% of pesticide residues from most produce. To actually break them down, you need a chemical reaction — not just water pressure. That’s exactly what PuriBreeze delivers.” Harvested, sorted, packed, loaded, unloaded, shelved, handled by other shoppers, bagged, and driven home. At every step, new contamination layers on top of the pesticide residues that were already there from day one. By the time they reach your fruit bowl, they carry the contamination of an entire supply chain. A 10-second rinse is not a meaningful response to that. Threat 1: Pesticides — Still There After Washing Pesticides aren’t designed to wash off. They’re engineered to BOND to the surface of fruit and vegetables so they survive rain, irrigation, and rough handling during transit. Think of it like waxing a car. Water beads right off the surface — the wax is still completely there. Pesticide residues work exactly the same way. Threat 2: Bacteria Your Fridge Isn’t Killing Cold storage doesn’t protect you — Listeria actually survives and multiplies at refrigerator temperatures. A single bag of spinach can carry THOUSANDS of bacterial colonies by the time it hits your bowl. Threat 3: The Spoilage You’re Blaming On Bad Luck One piece of fruit starting to decay releases microbial spores that speed up spoilage in everything around it. That’s why your raspberries go soft after two days and your lettuce wilts by Wednesday — it’s not bad luck, it’s contamination spreading. Properly purified produce lasts 3–5 days longer on average. *That last point matters financially. The average family throws away roughly $300 worth of produce every year purely because it spoils faster than it should. PuriBreeze at $79.99 pays for itself in saved groceries within weeks. For years, electrolysis-based purification was only available inside large commercial food processing facilities. The machines were the size of washing machines and cost tens of thousands of dollars. Here’s how it works: A small electrical current passes through water, creating charged particles powerful enough to break down pesticide molecules and destroy bacteria on contact. It doesn’t wash over contamination — it DISMANTLES it at a chemical level. The problem was that until now, the technology to do this was completely out of reach for regular families. A team of engineers — a food microbiologist, a chemical engineer, and a product designer — spent three years miniaturising that exact technology into something a regular family could use at home. No chemicals. No complex setup. Just one button. Here’s what’s happening in that bowl while you wait: Now in your kitchen. Removes 99% of pesticide residues — lab-tested, not just claimed Eliminates bacteria including E. coli, Salmonella, and Listeria Extends produce freshness by 3–5 days on average Zero chemicals — no residue, no aftertaste, no altered nutrition IPX7 fully waterproof — fully submersible Cordless and rechargeable — works anywhere One button — no settings, no learning curve Compact enough for travel ⭐⭐⭐⭐⭐ “Isn’t this complicated to use?” “Is it safe around food?” “I already buy organic. Do I need this?” “Why is it cheaper than I expected?” To keep costs as low as possible, the PuriBreeze team deliberately avoids retail channels. No middlemen, no store markups, no distributor fees. Just professional-grade purification technology shipped directly from the factory to your door. “We’re not in this for the margins,” says the lead engineer behind PuriBreeze. “After seeing just how much contamination the average family unknowingly consumes — and how much money gets thrown away in spoiled produce every year — our goal was simple: make this technology accessible to everyone. No family should have to choose between clean food and an affordable price.” Why you should act today: “Demand for PuriBreeze has consistently outpaced what we can produce,” explains the lead engineer. “Every unit goes through individual quality checks before it leaves the facility. The electrolysis components we use aren’t mass-produced — they’re precision parts, and we test every single one.” For the team, performance is non-negotiable. Any device that doesn’t generate the precise OH-ion concentration required to break down pesticide bonds and neutralise bacteria simply doesn’t ship. “We didn’t build a kitchen gadget. We built a precision purification instrument — the same category of technology trusted in hospitals and commercial food facilities. That level of quality control takes time. It’s why PuriBreeze has sold out multiple times this year alone. If you see ‘unavailable’ in the shop, we ask for your patience — the next tested batch is typically ready within three to four weeks.” Those who secure a unit get access to the same purification standard that industrial food facilities have relied on for decades — finally available for home use, at a price that makes sense. *As of March 4, 2026 — Ever since PuriBreeze was featured in major health and wellness publications, the response has been overwhelming. Due to its popularity and thousands of five-star reviews, the company is so confident in their product that they are now offering a one-time, first-time-buyer 70% discount. Click here to check if your discount is still available.
For years, there was no real solution available to regular families.The Contamination Journey: From The Farm To Your Family’s Plate
Consider what happens to a bunch of grapes before they reach your kitchen.Three Hidden Threats On EVERY Piece Of Produce In Your Kitchen Right Now
From Industrial Food Labs To Your Kitchen Counter

The Breakthrough: PuriBreeze
All you need to do is put PuriBreeze in a bowl of water with your produce, press the button, and let it run for five minutes.What it does How 💥 Destroys pesticide residues OH-ions break the molecular bonds holding residues to the skin — they don’t just rinse off, they break apart
🦠 Kills bacteria The same ions penetrate every crevice and surface, reaching bacteria that water pressure never could
✨ Leaves zero residue OH-ions are unstable — they react, break down, and disappear. NOTHING left behind
Same technology used in hospitals and industrial food facilities. What You Get With Every Use
What Families Are Saying
“I started using it after my youngest was diagnosed with a gut sensitivity that made foodborne bacteria genuinely dangerous for her. I’d been buying organic and still worrying. With this, I actually feel like I’m doing something that works. The water turns visibly murky within two minutes — which tells you everything you need to know about what was on the produce before.”
— Michelle T., Portland OR — Mother of two
⭐⭐⭐⭐⭐
“My mother is 74 and went through chemotherapy last year. Her immune system is still rebuilding. Her oncologist specifically warned us about produce contamination. This device gave us back confidence at mealtimes. She uses it every single day.”
— David R., Austin TX
⭐⭐⭐⭐⭐
“I’ll be honest — I was skeptical. Then I did a side-by-side test: same strawberries, same bowl, with and without the device. The water in the device bowl was grey. The plain water bowl was still clear. That was enough for me. It’s been on my counter for four months.”
— Sarah K., Chicago ILAnswering Commonly Asked Questions
One button. Fill a bowl with water. Put your produce in. Press the button. Five minutes later, quick rinse, done. No settings, no maintenance, no learning curve.
OH-ions occur naturally — produced by lightning and UV light acting on water vapour every day. They’re chemically unstable, meaning they react, break down, and vanish within seconds. By the time you rinse your produce, nothing remains. It’s the same reason the technology is trusted in hospital sterilisation.
Organic limits synthetic pesticides but doesn’t eliminate them — approved organic pesticides still exist, and cross-contamination from neighbouring farms is well-documented. More importantly, organic produce is just as exposed to bacterial contamination during handling and transit. The label doesn’t change the supply chain.
No retail markup. PuriBreeze is sold direct — no middlemen, no shelf fees, no distributor margins. You’re paying what it actually costs to make it, plus a fair margin. That’s it.Where Can I Buy The Original PuriBreeze?

“Quality Over Quantity”: Why PuriBreeze Keeps Selling Out














Started using PuriBreeze three weeks ago. Filled the bowl with water, ran it over some grapes, and the water turned grey within two minutes. I've been rinsing fruit my whole life thinking it was clean. Never again.